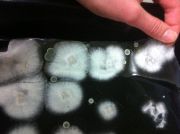
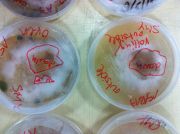
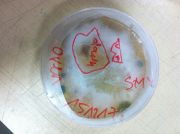

This special page shows all uploaded files.
| Date | Name | Thumbnail | Size | Description | Versions |
|---|---|---|---|---|---|
| 09:58, 19 April 2018 | Myfirstpatch.maxpat (file) | 12 KB | File uploaded with MsUpload | 1 | |
| 10:56, 18 March 2018 | Bildschirmfoto 2018-03-18 um 11.53.08.png (file) |  |
205 KB | File uploaded with MsUpload | 1 |
| 10:55, 18 March 2018 | Editorial.png (file) |  |
205 KB | File uploaded with MsUpload | 2 |
| 14:52, 11 February 2018 | Bildschirmfoto 2018-02-11 um 15.51.05.png (file) |  |
100 KB | File uploaded with MsUpload | 1 |
| 14:44, 11 February 2018 | Callforfungienglish Seite 1.jpg (file) |  |
236 KB | File uploaded with MsUpload | 1 |
| 13:57, 11 February 2018 | Callforfungi2 Seite 1.jpg (file) |  |
244 KB | File uploaded with MsUpload | 1 |
| 12:41, 11 February 2018 | 1218.JPG (file) |  |
190 KB | File uploaded with MsUpload | 1 |
| 12:38, 11 February 2018 | 1226.JPG (file) |  |
2.37 MB | File uploaded with MsUpload | 1 |
| 12:38, 11 February 2018 | 1231.JPG (file) |  |
2.24 MB | File uploaded with MsUpload | 1 |
| 12:38, 11 February 2018 | 1229.JPG (file) | |
1.68 MB | File uploaded with MsUpload | 1 |
| 12:26, 11 February 2018 | MycIdea3.jpg (file) |  |
199 KB | File uploaded with MsUpload | 1 |
| 12:26, 11 February 2018 | MycIdea2.jpg (file) |  |
202 KB | File uploaded with MsUpload | 1 |
| 12:26, 11 February 2018 | MycIdea1.jpg (file) |  |
135 KB | File uploaded with MsUpload | 1 |
| 12:12, 11 February 2018 | Biolab.jpg (file) |  |
113 KB | File uploaded with MsUpload | 1 |
| 12:11, 11 February 2018 | Bildschirmfoto 2018-02-11 um 13.10.37.png (file) |  |
753 KB | File uploaded with MsUpload | 1 |
| 12:10, 11 February 2018 | Myc&Gad.pdf (file) | 816 KB | File uploaded with MsUpload | 1 | |
| 11:29, 11 February 2018 | 1486.JPG (file) |  |
1.88 MB | File uploaded with MsUpload | 1 |
| 11:29, 11 February 2018 | 1485.JPG (file) |  |
2.1 MB | File uploaded with MsUpload | 1 |
| 11:29, 11 February 2018 | 1484.JPG (file) |  |
1.99 MB | File uploaded with MsUpload | 1 |
| 11:29, 11 February 2018 | 1483.JPG (file) |  |
2 MB | File uploaded with MsUpload | 1 |
| 11:29, 11 February 2018 | 1482.JPG (file) |  |
1.96 MB | File uploaded with MsUpload | 1 |
| 11:22, 11 February 2018 | CCI07012018 2.jpg (file) |  |
127 KB | File uploaded with MsUpload | 1 |
| 19:13, 14 January 2018 | PB080932.JPG (file) |  |
1.53 MB | File uploaded with MsUpload | 1 |
| 19:13, 14 January 2018 | PB080925.JPG (file) |  |
1.54 MB | File uploaded with MsUpload | 1 |
| 19:13, 14 January 2018 | PB080907.JPG (file) |  |
1.41 MB | File uploaded with MsUpload | 1 |
| 19:07, 14 January 2018 | PB080889.JPG (file) |  |
1.55 MB | File uploaded with MsUpload | 1 |
| 19:04, 14 January 2018 | PA310874.JPG (file) |  |
1.48 MB | File uploaded with MsUpload | 2 |
| 19:03, 14 January 2018 | PA310873.JPG (file) |  |
1.2 MB | File uploaded with MsUpload | 1 |
| 19:03, 14 January 2018 | PA310870.JPG (file) |  |
1.28 MB | File uploaded with MsUpload | 2 |
| 19:01, 14 January 2018 | PA310867.JPG (file) |  |
1.43 MB | File uploaded with MsUpload | 2 |
| 19:01, 14 January 2018 | PA310866.JPG (file) |  |
1.42 MB | File uploaded with MsUpload | 2 |
| 19:00, 14 January 2018 | PA310851.JPG (file) |  |
1.31 MB | File uploaded with MsUpload | 2 |
| 18:59, 14 January 2018 | PA310855.JPG (file) |  |
1.49 MB | File uploaded with MsUpload | 2 |
| 18:57, 14 January 2018 | PA310848.JPG (file) |  |
1.41 MB | File uploaded with MsUpload | 3 |
| 18:56, 14 January 2018 | PA310850.JPG (file) |  |
1.43 MB | File uploaded with MsUpload | 5 |
| 18:47, 14 January 2018 | PA310847.JPG (file) |  |
1.46 MB | File uploaded with MsUpload | 2 |
| 18:42, 14 January 2018 | PA310871.JPG (file) |  |
1.23 MB | File uploaded with MsUpload | 1 |
| 18:32, 14 January 2018 | PA300839.JPG (file) |  |
1.36 MB | File uploaded with MsUpload | 1 |
| 17:45, 10 January 2018 | IMG 1350.JPG (file) | |
2.22 MB | File uploaded with MsUpload | 1 |
| 17:45, 10 January 2018 | IMG 1349.JPG (file) |  |
2.18 MB | File uploaded with MsUpload | 1 |
| 17:45, 10 January 2018 | IMG 1353.JPG (file) |  |
2.27 MB | File uploaded with MsUpload | 1 |
| 17:45, 10 January 2018 | IMG 1352.JPG (file) |  |
2.25 MB | File uploaded with MsUpload | 1 |
| 17:45, 10 January 2018 | IMG 1351.JPG (file) |  |
2.19 MB | File uploaded with MsUpload | 1 |
| 17:35, 10 January 2018 | IMG 1342.JPG (file) |  |
2.16 MB | File uploaded with MsUpload | 1 |
| 17:35, 10 January 2018 | IMG 1341.JPG (file) |  |
2.04 MB | File uploaded with MsUpload | 1 |
| 17:35, 10 January 2018 | IMG 1340.JPG (file) |  |
1.91 MB | File uploaded with MsUpload | 1 |
| 17:35, 10 January 2018 | IMG 1339.JPG (file) |  |
1.84 MB | File uploaded with MsUpload | 1 |
| 17:35, 10 January 2018 | IMG 1348.JPG (file) | |
2.03 MB | File uploaded with MsUpload | 1 |
| 17:35, 10 January 2018 | IMG 1347.JPG (file) |  |
2.16 MB | File uploaded with MsUpload | 1 |
| 17:35, 10 January 2018 | IMG 1346.JPG (file) |  |
2.01 MB | File uploaded with MsUpload | 1 |